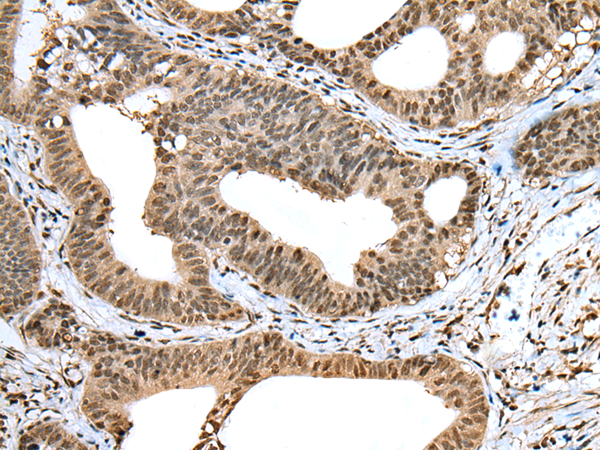

|
Background: |
The protein encoded by this gene belongs to the tigger subfamily of the pogo superfamily of DNA-mediated transposons in humans. These proteins are related to DNA transposons found in fungi and nematodes, and more distantly to the Tc1 and mariner transposases. They are also very similar to the major mammalian centromere protein B. The exact function of this gene is not known. |
|
Applications: |
ELISA, IHC |
|
Name of antibody: |
TIGD5 |
|
Immunogen: |
Fusion protein of human TIGD5 |
|
Full name: |
tigger transposable element derived 5 |
|
SwissProt: |
Q53EQ6 |
|
ELISA Recommended dilution: |
5000-10000 |
|
IHC positive control: |
Human gastric cancer and human thyroid cancer |
|
IHC Recommend dilution: |
25-100 |

購(gòu)物車(chē)
購(gòu)物車(chē) 幫助
幫助
 021-54845833/15800441009
021-54845833/15800441009
